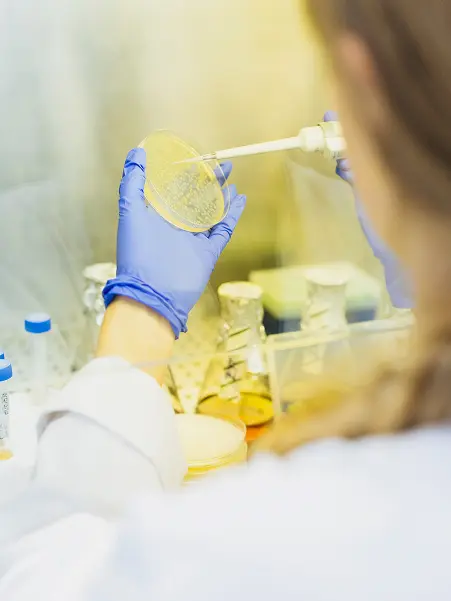

The fastest way to own
the right enzyme
Starting a biocatalysis campaign from the wrong place can quickly drain your budget. Identify the optimal starting point for all your enzyme ventures with data-driven certainty.
Need help navigating your enzyme journey?
Success stories
Reduce uncertainty.
Reach better outcomes
Trial-and-error cycles in enzyme engineering reduces yields and increases timelines. Our physics-AI hyperrealistic approach provides molecular-level insight, so you can take data-driven decisions and focus your efforts where success is most likely.
Lower development time from months to weeks
Switching to biocatalysis can become a lengthy process. Our unique approach accurately predicts performance early, saving you time and accelerating your path to success.
-
Secure ROI
75%
Less riskPrioritize top performers using robust data to guide resource allocation.
-
Accelerate your evolution
99%
Reduced lab workReduce millions of leads to the top 100 performers with rapid in silico analyses.
Reduce uncertainty.
Reach better outcomes
Trial-and-error cycles in enzyme engineering reduces yields and increases timelines. Our physics-AI hyperrealistic approach provides molecular-level insight, so you can take data-driven decisions and focus your efforts where success is most likely.
Secure ROI
75%
Less risk
Prioritize top performers using robust data to guide resource allocation.
Lower development time from months to weeks
Switching to biocatalysis can become a lengthy process. Our unique approach accurately predicts performance early, saving you time and accelerating your path to success.
Accelerate your evolution
99%
Reduced lab work
Reduce millions of leads to the top 100 performers with rapid in silico analyses.
Enzyme modeling this advanced? Only at Zymvol
Developed in-house by our team of experts, our physics-AI hyperrealistic approach accurately models enzyme function, enabling a lab-level understanding of molecular dynamics that drive real-world results.
Put better enzymes to work.
Everywhere
We support research and development across diverse industries, helping companies meet the demands of high performance while maintaining sustainability and cost-effectiveness.
+100
Projects
Driving innovation across diverse industries
+10
Countries
Expanding impact on a global scale
+70%
Repeat customers
From top leading companies
Great science happens at Zymvol
Our methodology is built on techniques validated through repeated peer review. We’re not just supporters of the scientific and industrial world—we’re shaping it from within.
-
-
Reliable Enzyme Innovation
-
-
Reliable Enzyme Innovation
-
-
Reliable Enzyme Innovation
-
-
Reliable Enzyme Innovation
Real results from years of enzyme expertise
Since 2017, we’ve pioneered the use of bioinformatics, molecular modelling and AI to accelerate innovation in biocatalysis with proven results.












